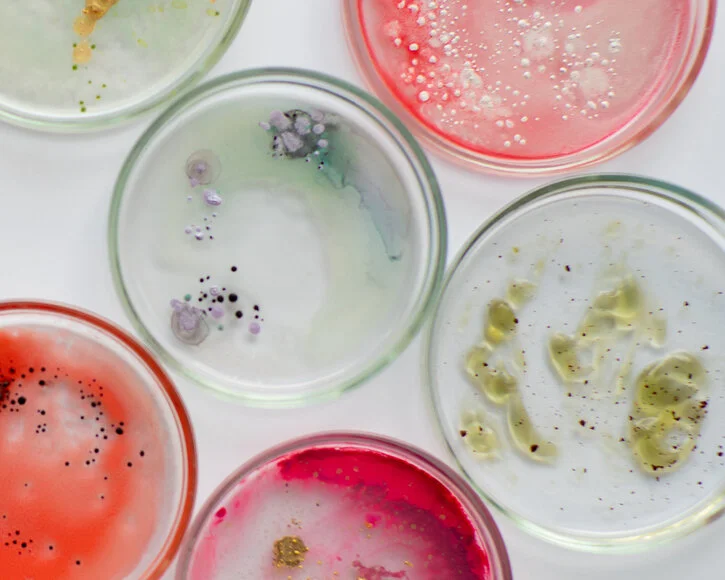
Neue Waffe gegen Krankenhauskeime in Arbeit

Kemintie ou Yhdystie 8156 est une rue d'Oulu en Finlande.
Présentation
Sur le côté nord de Tuira, la Kemintie menant du centre-ville d'Oulu au district de Kaijonharju croise la rue Bertel Jung menant de Toppila à la route 20.
Galerie
Notes et références
Voir aussi
Article connexe
Liens externes
- Oulun karttapalvelu - Oulun kaupunki
- Portail de l’architecture et de l’urbanisme
- Portail de la Finlande
Puolivälinkangas